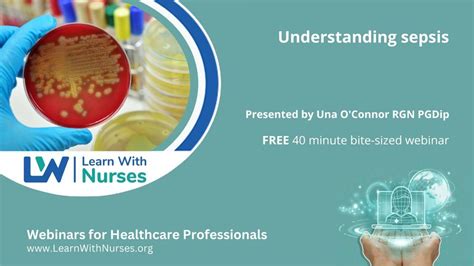

Understanding Psepsis In Healthcare
Understanding Psepsis in Healthcare
Hey guys! Today, we’re diving deep into a topic that’s super important in the healthcare world: psepsis . You might have heard the term thrown around, or maybe you’re completely new to it. Either way, stick around because we’re going to break down what psepsis really is, why it’s a big deal, and how healthcare professionals tackle it. Understanding psepsis in healthcare is crucial for anyone involved in patient care, from doctors and nurses to administrators and even patients themselves. It’s a complex condition, but by getting a solid grasp on its fundamentals, we can all contribute to better patient outcomes and safer healthcare environments. So, let’s get started on this journey to unravel the mysteries of psepsis!
Table of Contents
What Exactly is Psepsis?
So, what is psepsis ? At its core, psepsis is a life-threatening condition that arises when your body’s response to an infection damages its own tissues. Think of it as your immune system going into overdrive. Normally, your immune system fights off harmful germs like bacteria, viruses, and fungi. But in psepsis, something goes wrong. Instead of just targeting the infection, the immune system unleashes a widespread inflammatory response that can harm organs like the brain, heart, kidneys, and lungs. It’s not the infection itself that’s always the main culprit for the damage, but rather the body’s overreaction to it. This critical distinction is key to understanding psepsis. The initial infection could be something as common as a urinary tract infection (UTI), pneumonia, or even a skin infection. However, if this infection isn’t treated promptly and effectively, it can escalate. The body releases a flood of chemicals into the bloodstream to fight the infection, but these chemicals can trigger a cascade of inflammatory events. This inflammation causes blood vessels to leak fluid, leading to a drop in blood pressure. When blood pressure falls, vital organs don’t get enough oxygen and nutrients, and this is when the real danger begins. This is why recognizing psepsis early is so vital in a healthcare setting.
It’s important to differentiate psepsis from a simple infection. A localized infection, like a sore throat, usually triggers a localized inflammatory response. Your body sends immune cells to that specific area to clear the infection. But with psepsis, the infection enters the bloodstream or causes a systemic reaction, and the immune response becomes generalized throughout the body. This widespread inflammation is what makes psepsis so dangerous. It can quickly lead to organ dysfunction and failure if not managed aggressively. The severity of psepsis can range from mild to extremely severe. When it progresses to septic shock, it means the body’s blood pressure has dropped to dangerously low levels, and the organs are at high risk of permanent damage or failure. This is a medical emergency that requires immediate intervention. Understanding these nuances helps us appreciate the urgency and complexity involved in treating psepsis in healthcare . It’s a medical emergency that demands swift action, precise diagnosis, and a coordinated treatment approach.
The Dangers and Symptoms of Psepsis
Alright, guys, let’s talk about why psepsis is such a scary beast. The biggest danger with psepsis is its speed and severity. It can go from a manageable infection to a life-threatening condition in a matter of hours. That rapid progression is what makes early detection of psepsis absolutely critical in any healthcare setting. When the body’s organs aren’t getting enough blood flow due to low blood pressure, they start to shut down. This can lead to serious complications like kidney failure, respiratory distress, heart problems, and even brain damage. If left untreated, psepsis can quickly lead to septic shock, a state of extreme danger where blood pressure plummets so low that it can no longer sustain vital organ function. Septic shock has a high mortality rate, which underscores the urgency of recognizing and treating psepsis the moment it’s suspected. The symptoms of psepsis can be tricky because they often mimic other conditions, especially in the early stages. This is where healthcare professionals rely on their training and experience. Some common signs and symptoms that might indicate psepsis include:
- High heart rate: Your heart might beat much faster than normal.
- Fever or feeling very cold: You might have a high temperature, or you might feel shivery and cold.
- Confusion or disorientation: This is a big one, guys. A sudden change in mental state, like not knowing where you are or difficulty thinking clearly, can be a sign.
- Shortness of breath: You might find it hard to breathe or feel like you’re not getting enough air.
- Extreme pain or discomfort: This can manifest as feeling generally unwell or having severe pain that’s hard to pinpoint.
- Clammy or sweaty skin: Your skin might feel cool and moist.
It’s super important to remember that not everyone will experience all of these symptoms. Sometimes, older adults or people with chronic illnesses might present with less obvious signs, like a general decline in function or increased sleepiness. This is why a high index of suspicion is necessary when caring for vulnerable populations. Recognizing the subtle signs of psepsis is a skill honed through experience and constant vigilance. In healthcare, the mantra is often: when in doubt, check for psepsis . The faster these symptoms are recognized and acted upon, the better the chances of survival and recovery. The impact of delayed diagnosis can be devastating, turning a potentially treatable infection into a life-altering or fatal event. That’s why psepsis awareness campaigns and continuous education for healthcare providers are so crucial.
How Healthcare Professionals Diagnose and Treat Psepsis
When it comes to psepsis in healthcare , diagnosis and treatment are a race against time, folks. Healthcare professionals have a whole arsenal of tools and strategies to identify and combat this life-threatening condition. The first step is always a thorough clinical assessment. This involves listening carefully to the patient’s symptoms, checking vital signs like blood pressure, heart rate, and temperature, and performing a physical examination. Doctors and nurses are trained to look for that constellation of symptoms we just talked about – confusion, rapid breathing, high heart rate, and signs of poor perfusion (like cool, clammy skin). This initial suspicion is key. If psepsis is suspected, the next critical step is to confirm the presence of an infection and identify the causative microorganism. This is usually done through laboratory tests. Blood tests are essential. They can reveal signs of infection, such as an elevated white blood cell count, and check for markers of inflammation. Blood cultures are vital because they aim to grow the bacteria or fungi causing the infection, allowing doctors to identify the specific germ and determine which antibiotics will be most effective. Other tests might include urine cultures, chest X-rays (to check for pneumonia), or wound cultures, depending on the suspected source of the infection. The goal is to pinpoint the infection quickly.
Once an infection is identified and psepsis is strongly suspected, the treatment must begin immediately . The cornerstone of psepsis treatment is early administration of antibiotics . Broad-spectrum antibiotics are typically given first, meaning they are effective against a wide range of bacteria. Once the specific pathogen is identified from the cultures, these antibiotics can be narrowed down to target that particular germ more effectively. This is often referred to as de-escalation of antibiotics , which helps reduce the risk of antibiotic resistance. Alongside antibiotics, fluid resuscitation is crucial. Large volumes of intravenous (IV) fluids are given rapidly to help restore blood pressure and improve blood flow to the organs. If fluids alone aren’t enough to raise blood pressure, doctors may administer vasopressor medications . These drugs constrict blood vessels, helping to increase blood pressure and ensure that vital organs continue to receive oxygenated blood. Oxygen therapy is also standard to ensure adequate oxygenation of the blood. In more severe cases, patients might require mechanical ventilation to assist with breathing. Sometimes, source control is necessary. This means surgically removing or draining infected tissues, such as draining an abscess or removing infected medical devices. This removes the source of the infection, making it easier for the antibiotics and the body’s immune system to clear the remaining germs. The entire process is often managed by a multidisciplinary team, including intensivists, infectious disease specialists, surgeons, and nurses, all working together to provide comprehensive care. The promptness and coordination of these interventions are what make the difference between life and death when dealing with psepsis in healthcare .
Preventing Psepsis in Healthcare Settings
Prevention, guys, is always better than cure, especially when it comes to something as serious as psepsis . In healthcare settings, there are a ton of measures in place to prevent infections that can lead to psepsis . These strategies are implemented at every level, from individual patient care to hospital-wide policies. One of the absolute cornerstones of prevention is meticulous hand hygiene . Healthcare workers are trained to wash their hands thoroughly with soap and water or use alcohol-based hand sanitizers before and after interacting with patients, procedures, and even just touching surfaces in patient rooms. This simple act is incredibly effective at stopping the spread of germs. Another key area is sterilization and disinfection . All medical equipment, instruments, and even surfaces in the healthcare environment are rigorously cleaned, disinfected, and sterilized to eliminate any potential pathogens. Think about surgical tools, IV lines, and even bed rails – everything needs to be kept scrupulously clean. Infection control protocols are also paramount. Hospitals have dedicated infection control teams that monitor for outbreaks, track infection rates, and implement best practices. This includes procedures for managing catheters (like urinary catheters and central venous lines), which can sometimes become entry points for bacteria if not properly cared for. Minimizing the use of invasive devices whenever possible is also a strategy, as these devices can increase the risk of infection. Vaccination is another crucial preventive measure, not just for patients but also for healthcare workers themselves. Vaccines for influenza and pneumococcal disease, for example, can prevent common infections that might otherwise lead to severe illness and psepsis.
Furthermore, patient education plays a vital role. Empowering patients to understand their own health conditions and to speak up if they feel something isn’t right is incredibly important. For instance, patients with chronic conditions like diabetes or those undergoing chemotherapy are at higher risk for infections, and they need to be aware of the signs of infection and when to seek medical attention. Healthcare providers also focus on safe prescribing practices for antibiotics. This means ensuring that antibiotics are only used when necessary and that patients complete their full course of treatment. Overuse and misuse of antibiotics contribute to the development of antibiotic-resistant bacteria, making infections harder to treat and increasing the risk of psepsis. Finally, creating a culture of safety within healthcare organizations is fundamental. This involves encouraging open communication, where healthcare professionals feel comfortable reporting potential errors or near misses without fear of reprisal. It’s about continuous learning and improvement, constantly reviewing processes, and implementing changes based on evidence and experience. By focusing on these preventative measures, healthcare systems aim to reduce the incidence of infections, thereby significantly lowering the risk of patients developing psepsis . It’s a massive team effort, and every single person involved in healthcare plays a part in this vital mission.
The Future of Psepsis Management
Looking ahead, the future of psepsis management in healthcare is incredibly exciting, guys! While we’ve made huge strides, researchers and clinicians are constantly working on innovative ways to improve how we detect, treat, and prevent psepsis. One of the most promising areas is early detection through advanced diagnostics . Scientists are developing new biomarkers – specific molecules in the blood or other bodily fluids – that can signal the presence of psepsis much earlier than current methods. Imagine a simple blood test that could tell doctors within minutes if a patient is developing psepsis, allowing for immediate intervention. Artificial intelligence (AI) and machine learning are also set to revolutionize psepsis care. AI algorithms can analyze vast amounts of patient data – vital signs, lab results, electronic health records – to identify subtle patterns that might indicate a patient is at high risk for psepsis, even before clear symptoms emerge. This predictive capability could be a game-changer for proactive treatment. In terms of treatment, the focus is on personalized medicine . Instead of a one-size-fits-all approach, future treatments will likely be tailored to the individual patient’s specific infection, genetic makeup, and immune response. This could involve using targeted therapies that are more effective and have fewer side effects. Novel antimicrobial agents are also a major area of research, aimed at combating the growing threat of antibiotic-resistant bacteria. Developing new drugs and alternative treatments, like phage therapy, could provide much-needed weapons against superbugs. Furthermore, there’s a growing emphasis on patient recovery and long-term outcomes . Psepsis survivors often face significant long-term health challenges, known as post-sepsis syndrome, which can include cognitive impairment, fatigue, and mental health issues. Future research and clinical practice will focus more on comprehensive rehabilitation programs and support systems to help patients regain their quality of life after surviving psepsis. The goal is not just to save lives but to ensure survivors can thrive. Collaboration between researchers, clinicians, policymakers, and even patient advocacy groups will be crucial in driving these advancements. By embracing new technologies and fostering a culture of continuous improvement, we can look forward to a future where psepsis in healthcare is managed more effectively, leading to better outcomes and fewer lives lost to this devastating condition. It’s an ongoing battle, but one we are increasingly equipped to fight.
Conclusion
So there you have it, guys! We’ve journeyed through the complexities of psepsis in healthcare , from understanding what it is and why it’s so dangerous, to how it’s diagnosed and treated, and even how we’re working to prevent it. Psepsis is undoubtedly a formidable challenge, but with the knowledge and tools available to healthcare professionals today, and with the relentless pursuit of innovation, we are better equipped than ever to face it. Remember, early recognition and prompt treatment are the most critical factors in improving outcomes for patients with psepsis. If you or a loved one ever experience symptoms that worry you, don’t hesitate to seek medical attention immediately. Being informed is your first line of defense. The continuous efforts in psepsis prevention within healthcare settings, coupled with groundbreaking research into diagnostics and treatments, offer a hopeful outlook for the future. It’s a testament to the dedication of healthcare professionals and researchers worldwide. Thanks for tuning in, and let’s all stay vigilant and informed!